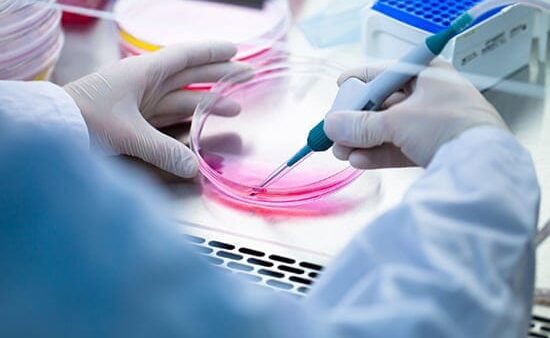

最近、髪のボリューム気になりませんか?
年齢と共に進む「髪の変化」感じていませんか?
「抜け毛が増えた」「髪が細くなった」「分け目が目立つ」…
それは、髪の“老化”ではなく、頭皮環境の変化が原因かもしれません。
強髪プログラムは、再生美容成分「ヒト幹細胞培養液」を使用し、細胞レベルで頭皮を整え「育てる髪」の土台をつくります。
こんなお悩みありませんか?
- 最近、抜け毛が増えてきた気がする
- 分け目やつむじのペタンが気になってきた
- 髪のハリ・コシがなくなり、老けて見える
- 頭皮の乾燥やかゆみが気になる
- 年齢に合った本格的なケアを探している
そんなあなたへ、頭皮からのケアを。
強髪プログラムとは?

強髪とは
「髪人生を原点から変えていく 次世代のヘアケア」をブランドコンセプトに全国の美容室やエステサロン、鍼灸整骨院で取り扱われている施術メニューです。
原点から変えていくとは、今の髪の毛をケアするトリートメントではなく、これから生えてくる髪の毛を頭皮からケアしていく次世代のヘアケアです。

「いつまでも、若く、美しく」を届けます
強髪は毛髪環境を根本から見直します。
抜け毛や切れ毛、細毛、ぺたんこ髪など頭皮の悩みを解決に導くために、従来のコーティング(皮膜)系トリートメントではなく、頭皮に直接作用する有効成分を気になる部分に直接塗布して、専用のポレーションで浸透を促す施術になります。
年齢や性別を問わず、月に1~2回の施術を継続することで、健康な肌と頭皮、そして強い髪を目指していきます。
美しさを提供する最先端の研究から開発された成分ヒト幹細胞上清液とは?
ヒトの幹細胞を培養した際に得られる上澄み液のことで、幹細胞から分泌された成長因子やサイトカイン、エクソソームなどの有用成分が豊富に含まれています。
この液体は、細胞や組織の修復や再生を促進する効果が期待され、医療や美容分野で広く活用されています。

アーユルヴェーダハーブエキスとは?
5,000年の歴史をもつインド・スリランカ発祥の伝承医学として知られるアーユルヴェーダハーブは、サンスクリット語のアーユ(Ayus/生命)とヴェーダ(Veda/科学)が融合した生命科学が源です。
アーユルヴェーダの掛け合わせ効果を実証すべく、皮膚科学と組み合わせながら細胞試験をおこない頭皮環境の改善を目指す有効なハーブを効果的に活用しております。
強力な育毛効果
ヒト幹細胞培養液は、ターンオーバーのサイクルを“短く”できる能力を持っています。
ターンオーバーとは、細胞が死んで新しく生まれ変わること。
ターンオーバーのサイクルは、年齢を重ねるごとにどんどん長くなり、細胞が、なかなか新しくならなくなっていきます。
そうすると、頭皮の細胞にも元気がなくなり、どんどん髪のボリュームが少なくなっていきます。
強髪プログラムは、成長因子である「グロスファクター」をたくさん含んでいるヒト幹細胞培養液と、育毛に効果のある厳選された「アーユルヴェーダハーブ」を配合したものを、ダイレクトに頭皮に与えることで、ターンオーバーのサイクルを早くし、頭皮をより健康な状態へ変えていくことができます。
また、毛母細胞の成長を活性化し強く、太い毛を育てるようになります。毛髪の生成ができなくなった毛母細胞もヒト幹細胞培養液を与えることで、発毛するケースがあります。(薄毛・細毛・うねり・白髪・ハリコシ)
施術はシャンプー後に、塗布と浸透のみ

専用ポレーションによる浸透 イメージ動画です